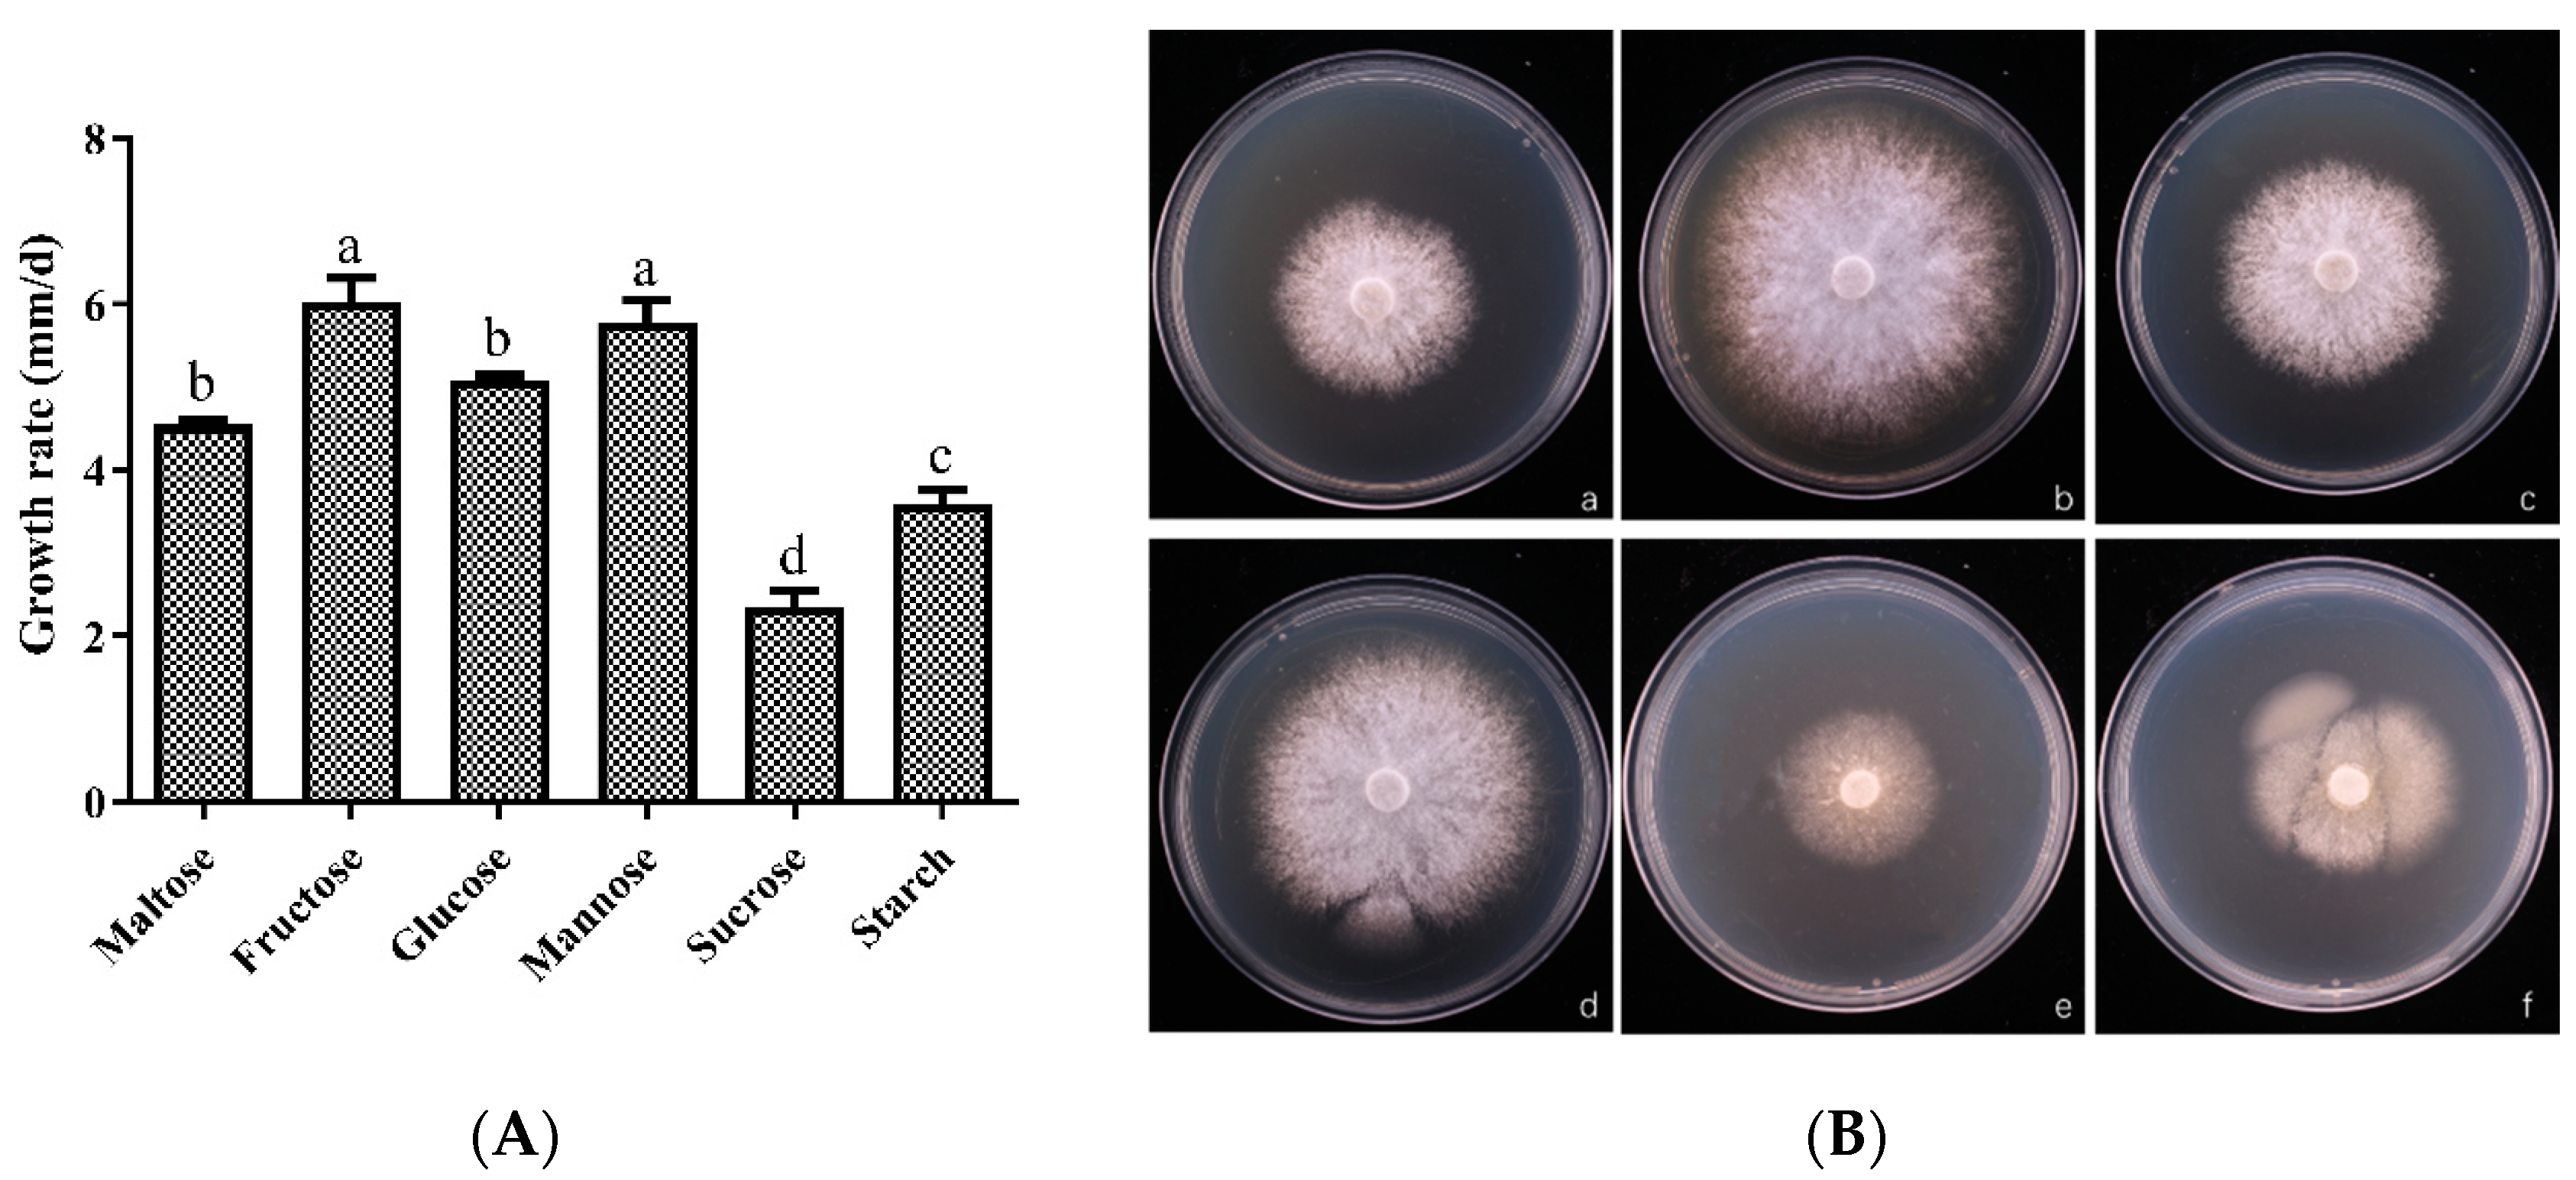
Horticulturae 10 01177 g003
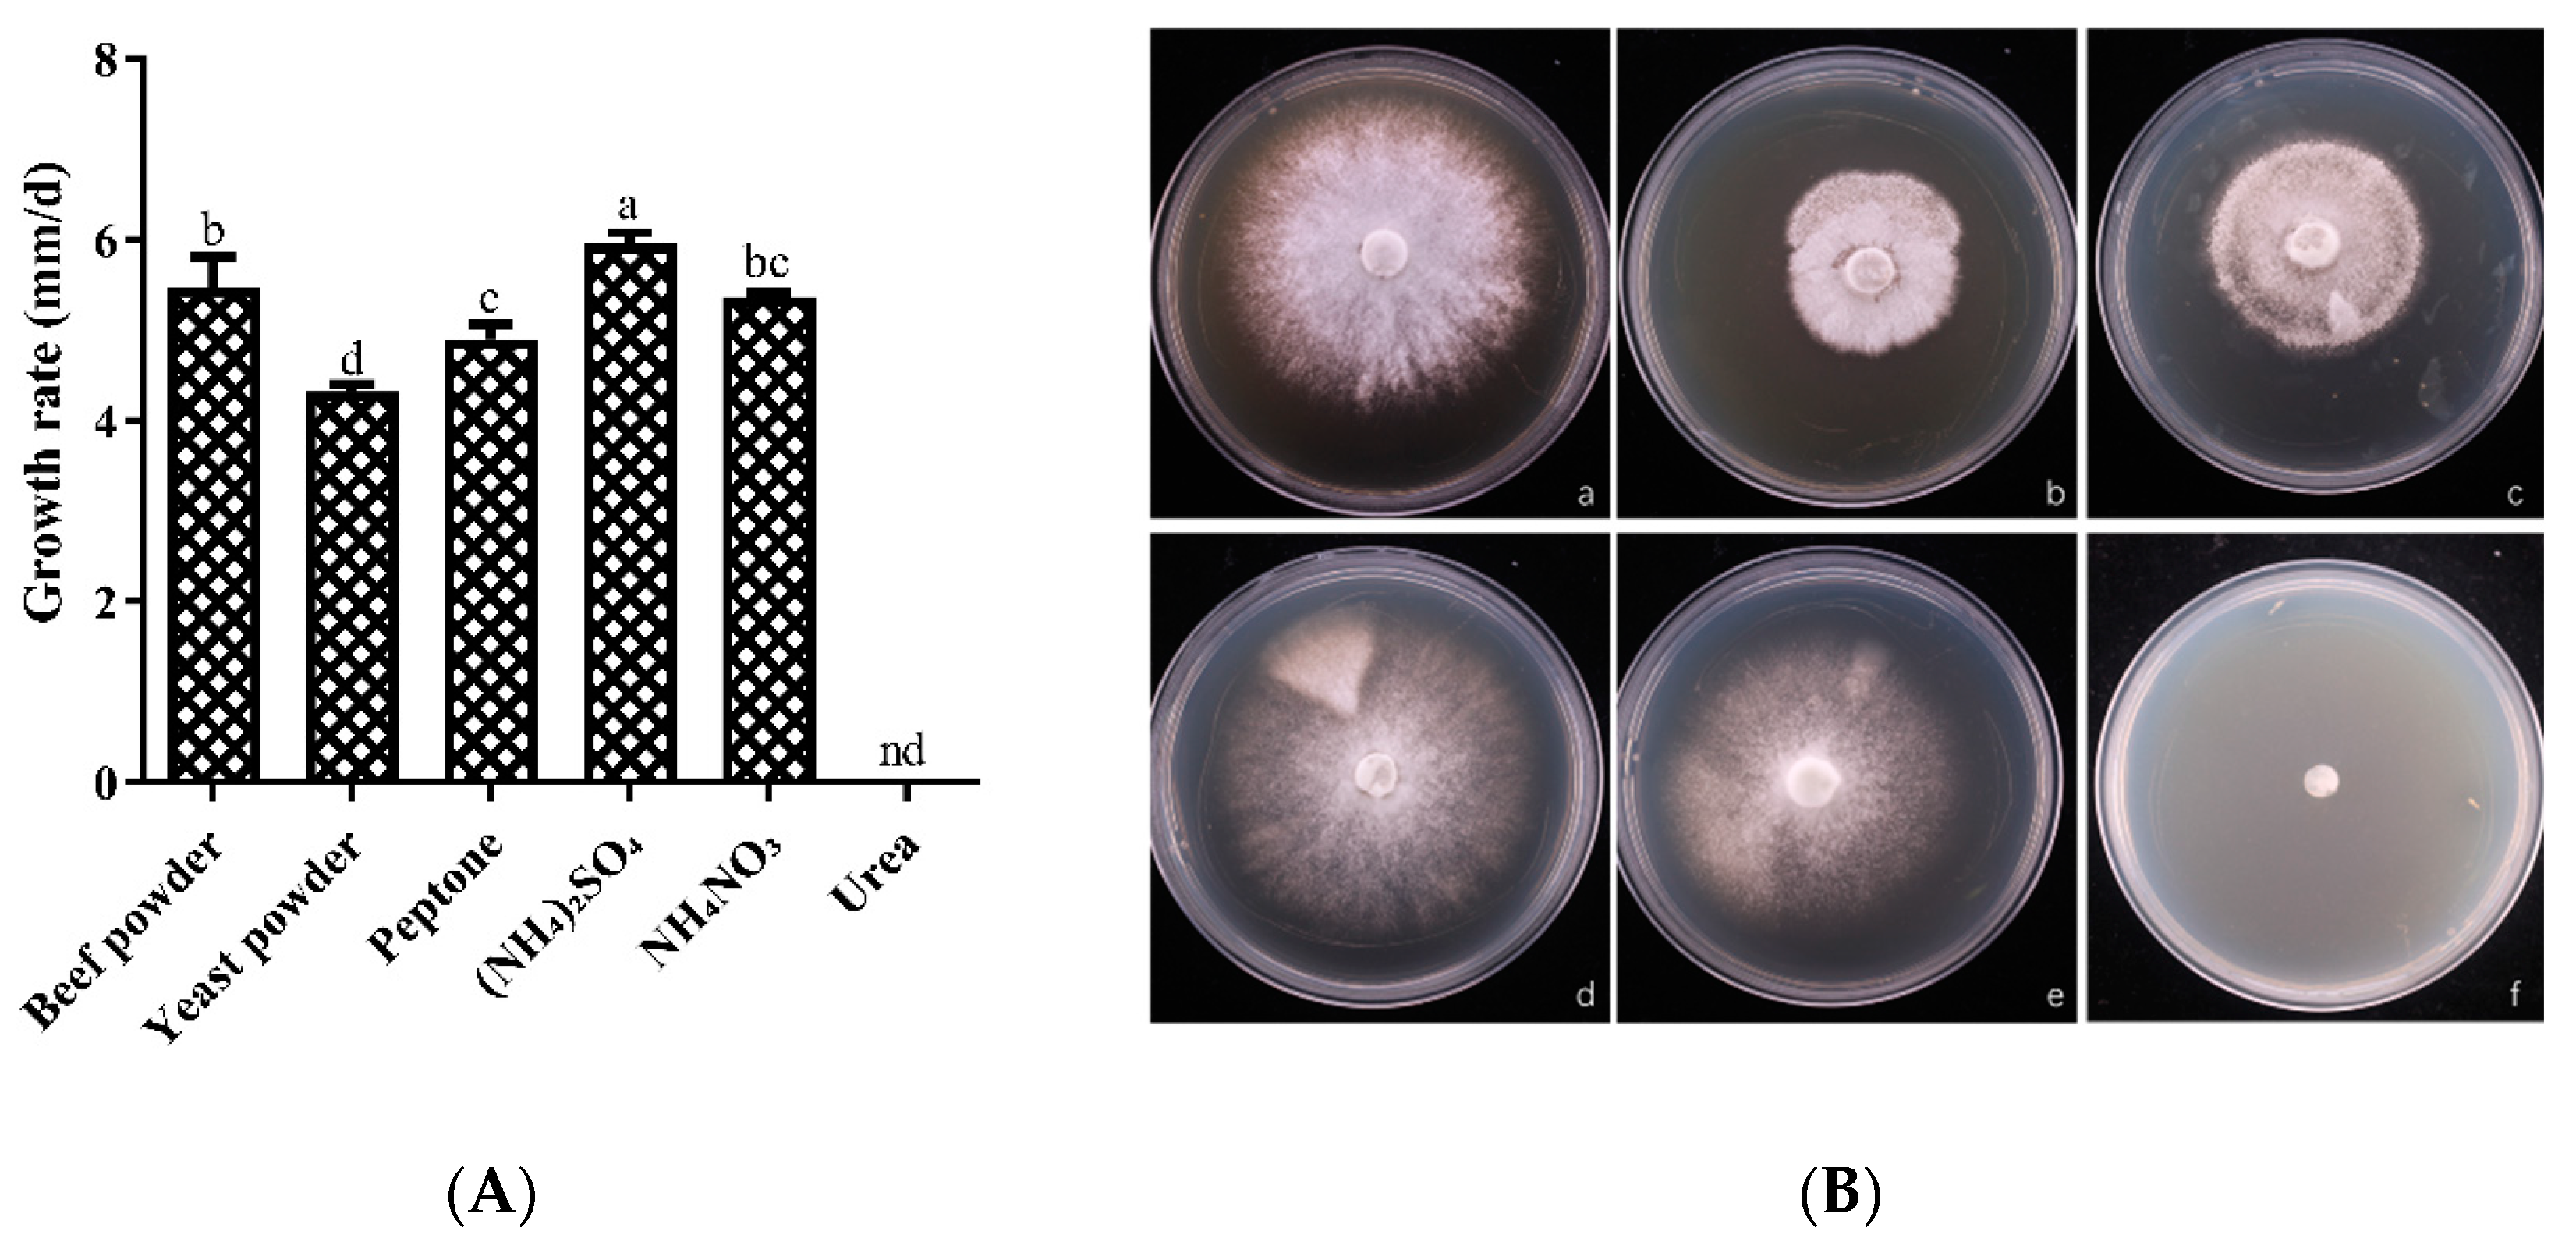
Horticulturae 10 01177 g004
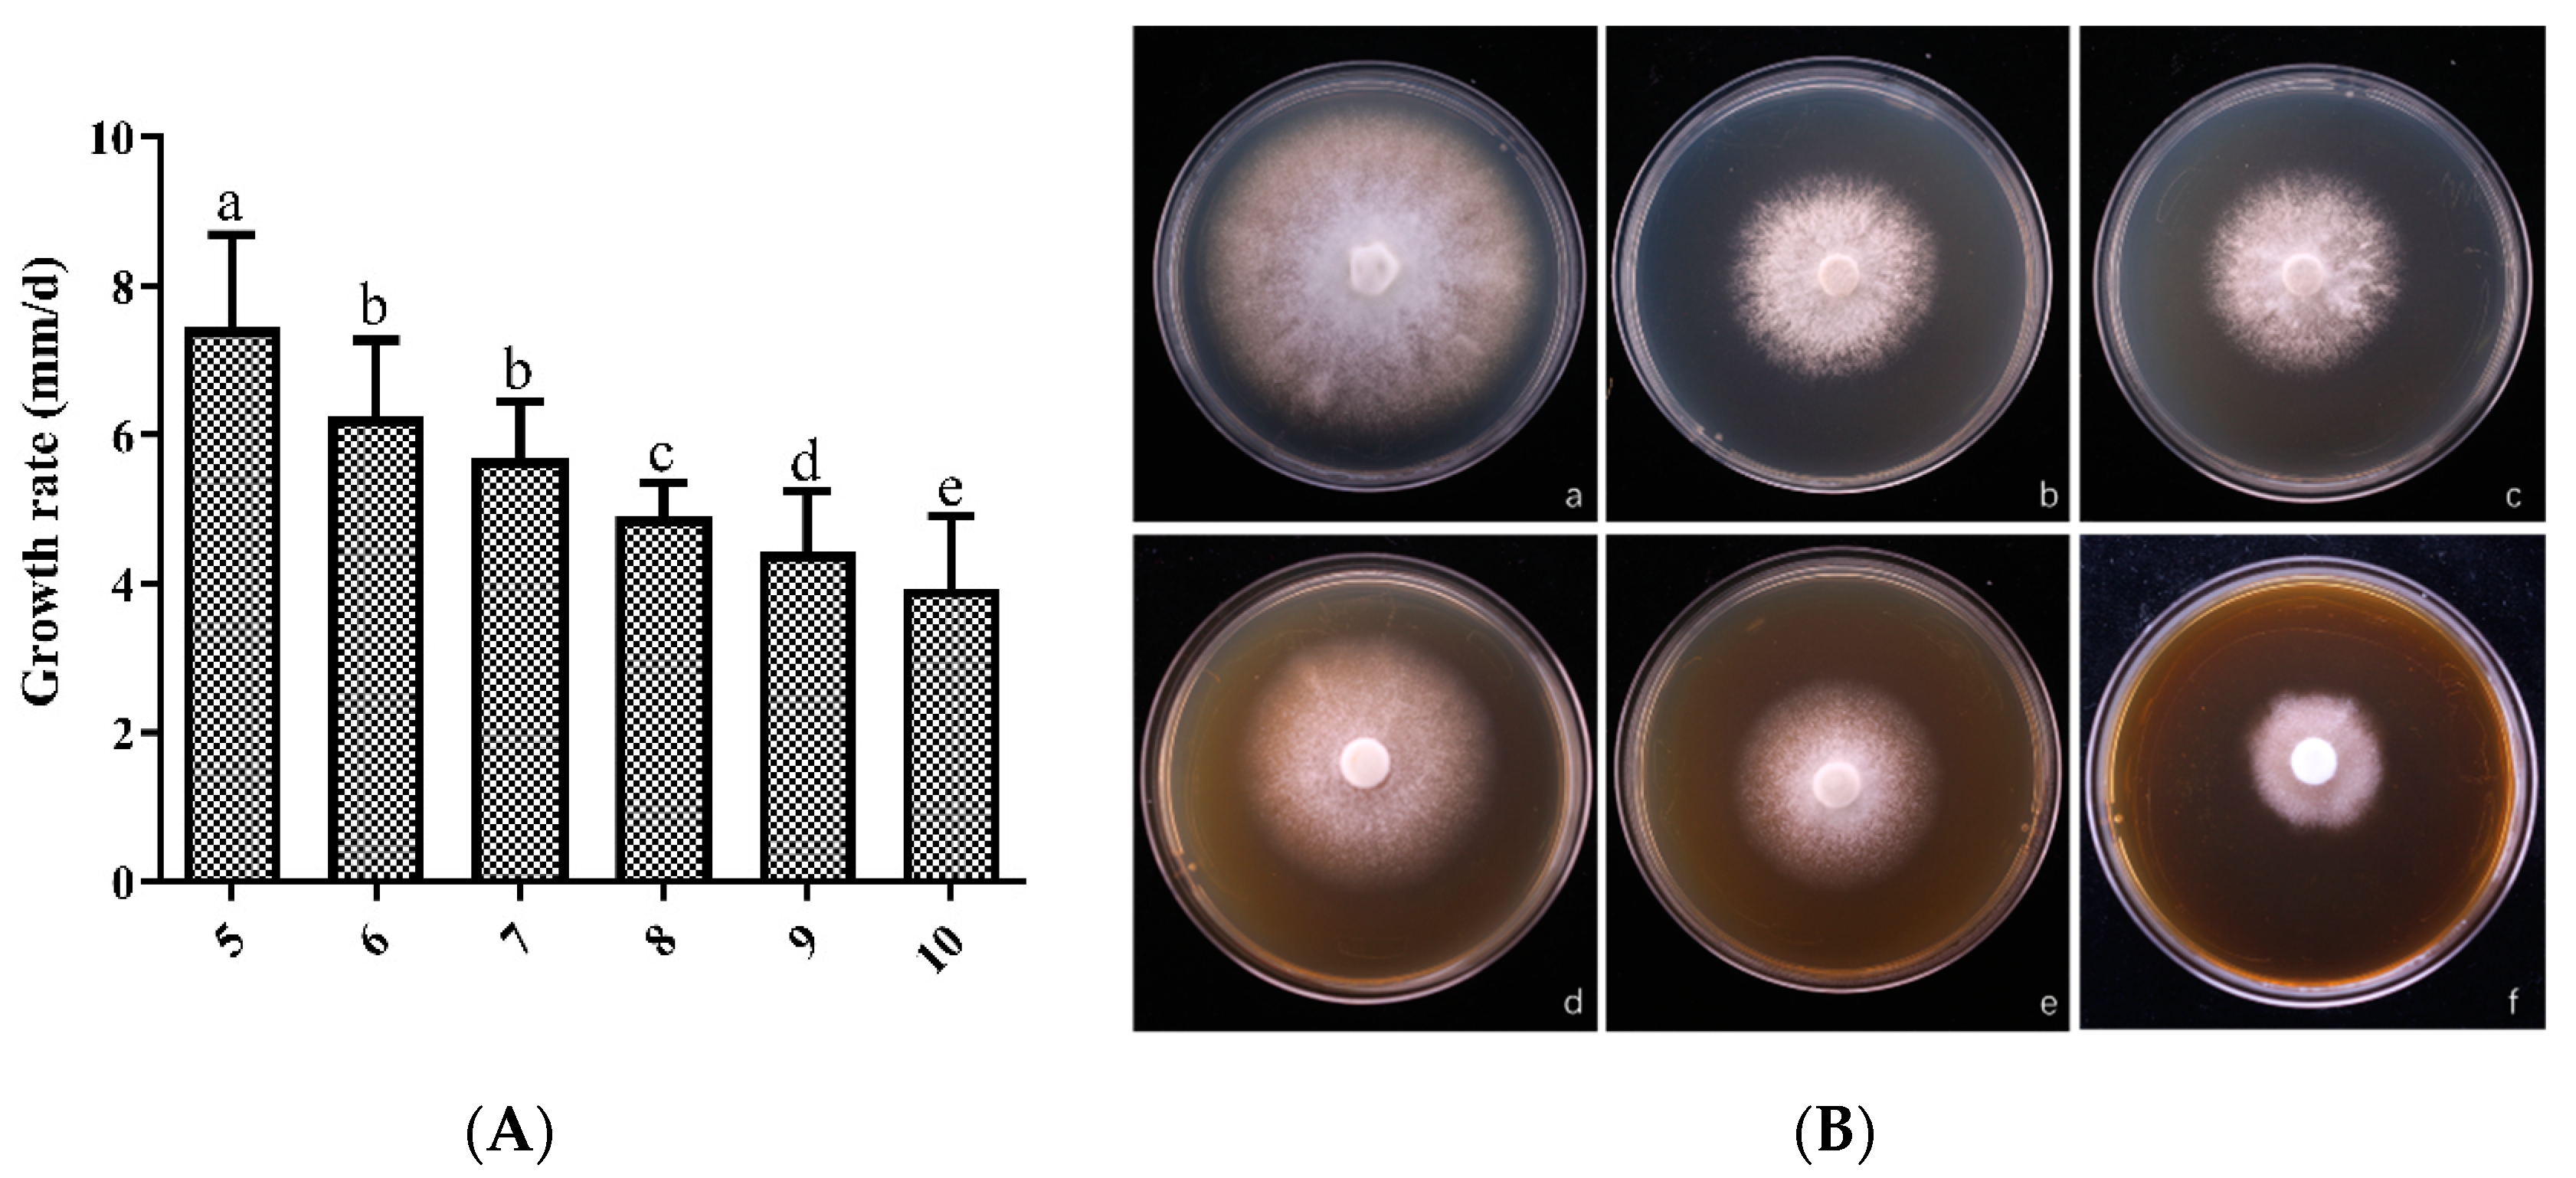
Horticulturae 10 01177 g005

Biological Characteristics, Domestication and Cultivation of Wild Tyromyces kmetii
Abstract
1. Introduction
2. Materials and Methods
2.1. Samples
2.2. Morphological Identification
2.3. Molecular Biology and Phylogenetic Analysis
2.4. Biological Characteristics Study
2.4.1. Effect of Carbon Sources on Hyphal Growth
2.4.2. Effect of Nitrogen Sources on Hyphal Growth
2.4.3. Effect of pH on Hyphal Growth
2.4.4. Effect of Temperature on Hyphal Growth
2.5. Domestication and Cultivation
2.5.1. Seed Preparation
2.5.2. Bagging and Cultivation
2.6. Statistical Analysis
3. Results
3.1. Morphological Observation
3.2. Molecular Biology Identification and Phylogenetic Analysis
3.3. Biological Characteristics Analysis
3.3.1. Impact of Carbon Sources on Hyphal Growth
3.3.2. Impact of Nitrogen Sources on Hyphal Growth
3.3.3. Impact of pH on Hyphal Growth
3.3.4. Impact of Temperature on Hyphal Growth
3.4. Cultivation Results
4. Discussion
Author Contributions
Funding
Data Availability Statement
Conflicts of Interest
References
- Bondartsev, G.N.; Singer, R. Tyromyces kmetii (Bres.) Bondartsev & Singer. Ann. Mycol. 1941, 39, 52. [Google Scholar]
- Li, Y.; Li, T.; Yang, Z.; Tuliguer; Dai, Y. China Large Scale Fungal Resources Atlas; Zhongyuan Publishing Media Group Dadi Media, Zhongyuan Farmers Publishing House: Zhengzhou, China, 2015. [Google Scholar]
- Zhao, J. Flora of Fungi in China (Volume 3, Poroobacteriaceae); Science Press: Beijing, China, 1998. [Google Scholar]
- Miettinen, O.; Vlasák, J.; Larsson, E.; Seelan, J.S.S.; Levicky, Q.; Larsson, K.H.; Spirin, V. A revised genus-level classification for Cerrenaceae (Polyporales, Agaricomycetes). Fungal Syst. Evol. 2023, 12, 271–322. [Google Scholar] [CrossRef] [PubMed]
- Park, M.S.; Cho, H.J.; Kim, N.K.; Park, J.Y.; Lee, H.; Park, K.H.; Kim, M.J.; Kim, J.J.; Kim, C. Ten New Recorded Species of Macrofungi on Ulleung Island, Korea. Mycobiology 2017, 45, 286–296. [Google Scholar] [CrossRef]
- Liu, T.; Li, G. Atlas of Large Scale Fungi in Saihanwula, Inner Mongolia; Inner Mongolia Science and Technology Press: Chifeng, China, 2019. [Google Scholar]
- Shao, M.; Zhu, B.; Li, M.; Li, H. Research progress on the application of white rot fungi in environmental protection. J. Jinling Univ. Sci. Technol. 2015, 31, 88–92. [Google Scholar]
- Wei, Y.; Dai, Y. The function of wood decay fungi in forest ecosystems. J. Appl. Ecol. 2004, 15, 1935–1938. [Google Scholar]
- Dai, G. Research Progress on Degradation of Agricultural Waste Straw by white Rot Fungi. J. Liaoning Univ. Sci. Technol. 2020, 22, 17–19. [Google Scholar]
- Wang, X.; Li, Z.; Ni, Z.; Song, L. Research Progress on the Degradation of Pesticides by White Rot Fungi. J. Pestic. Sci. 2020, 22, 405–412. [Google Scholar]
- Huang, N. A Color Atlas of Large Fungi in China; China Agricultural Publishing House: Beijing, China, 1998. [Google Scholar]
- Hu, X.; Yang, R.; Wu, D.; Zhu, X.; Wu, X.; Fu, J. Antioxidant and anti-Huh7 hepatocarcinoma cell activities of polysaccharides from a strain of Trametes sanguinea. J. Microbiol. 2023, 42, 793–807. [Google Scholar]
- Cao, W.; Zhao, Y.; Yang, S.; Lin, Q.; Deng, C.; Li, C. Domestication and bioactive components of Polycephalomyces ramosus. Mycosystema 2024, 43, 230254. [Google Scholar]
- Gao, Z.; Han, H.; Feng, L.; Cheng, X.; Zhang, J.; Wang, X.; Sun, W. Domestic cultivation of Trametes sanguinea. Mycosystema 2024. [Google Scholar] [CrossRef]
- Qi, Z.; Rao, G.; Hu, J.; Tuo, Y.; Zhang, B.; Qian, K. Biological characteristics and artificial domestication cultivation of Tyromyces chioneus. Mycosystema 2023, 42, 408–4171. [Google Scholar]
- Zhang, F.; Zhang, T.; Li, D.; Zhang, B.; Li, Y. Biological characteristics, domestication cultivation and antioxidant activity of Trametes gibbosa. J. Microbiol. 2019, 38, 1480–1490. [Google Scholar]
- Tian, R.; Chen, L.; Zhao, R.; Zeng, N. Biological characteristics and cultivation of Ganoderma subflexipes. Mycosystema 2024, 43, 240087. [Google Scholar]
- Mo, W.; Liu, Y.; Hu, H.; Huang, L.; Liang, X.; Xie, Y.; Tenzin, T. Preliminary Study on Biological Characteristics of Ganoderma leucocontextum. Chin. Edible Fungi 2017, 36, 33–38. [Google Scholar]
- Liang, Y.; Dai, D.; Rao, G.; Li, D.; Yu, H. Biological characteristics, domestic cultivation and antioxidant activities of Fomitopsis ostreiformis. J. Microbiol. 2021, 40, 2074s–2086s. [Google Scholar]
- Carrasco, J.; Zied, D.C.; Pardo, J.E.; Preston, G.M.; Pardo-Giménez, A. Supplementation in mushroom crops and its impact on yield and quality. AMB Express 2018, 8, 146. [Google Scholar] [CrossRef] [PubMed]

| PDA | PDB | Substrate | |||
|---|---|---|---|---|---|
| Ingredient | Content | Ingredient | Content | Ingredient | Content |
| Potatoes | 20% | Potatoes | 20% | Miscellaneous woodchips | 60% |
| Glucose | 2% | Glucose | 2% | Cottonseed shell | 20% |
| MgSO4 | 0.15% | MgSO4 | 0.15% | Wheat bran | 18% |
| KH2PO4 | 0.2% | KH2PO4 | 0.2% | Lime | 1% |
| Vitamin B1 | 0.001% | Vitamin B1 | 0.001% | Sucrose | 1% |
| Agar | 2% | pH | 7.0 | Moisture content | 65% |
| pH | 7.0 | pH | 7.0 | ||
| Amplification System | Amplification Program | |||
|---|---|---|---|---|
| DNA | 2 μL | 95 °C | 3 min | |
| ITS1 | 2 μL | 95 °C | 15 s | 35 Cycles |
| ITS4 | 2 μL | 58 °C | 15 s | |
| ddH2O | 19 μL | 72 °C | 60 s | |
| Taq | 25 μL | 72 °C | 5 min | |
| Total | 50 μL | 4 °C | Forever | |
Disclaimer/Publisher’s Note: The statements, opinions and data contained in all publications are solely those of the individual author(s) and contributor(s) and not of MDPI and/or the editor(s). MDPI and/or the editor(s) disclaim responsibility for any injury to people or property resulting from any ideas, methods, instructions or products referred to in the content. |
© 2024 by the authors. Licensee MDPI, Basel, Switzerland. This article is an open access article distributed under the terms and conditions of the Creative Commons Attribution (CC BY) license (https://creativecommons.org/licenses/by/4.0/).
Share and Cite
Huang, H.; Li, X.; Hu, X.; Sun, H.; Zhang, J.; Wu, X.; Fu, J. Biological Characteristics, Domestication and Cultivation of Wild Tyromyces kmetii. Horticulturae 2024, 10, 1177. https://doi.org/10.3390/horticulturae10111177
Huang H, Li X, Hu X, Sun H, Zhang J, Wu X, Fu J. Biological Characteristics, Domestication and Cultivation of Wild Tyromyces kmetii. Horticulturae. 2024; 10(11):1177. https://doi.org/10.3390/horticulturae10111177
Chicago/Turabian StyleHuang, Haichen, Xiaomin Li, Xin Hu, Huijuan Sun, Junli Zhang, Xiaoping Wu, and Junsheng Fu. 2024. "Biological Characteristics, Domestication and Cultivation of Wild Tyromyces kmetii" Horticulturae 10, no. 11: 1177. https://doi.org/10.3390/horticulturae10111177
APA StyleHuang, H., Li, X., Hu, X., Sun, H., Zhang, J., Wu, X., & Fu, J. (2024). Biological Characteristics, Domestication and Cultivation of Wild Tyromyces kmetii. Horticulturae, 10(11), 1177. https://doi.org/10.3390/horticulturae10111177






